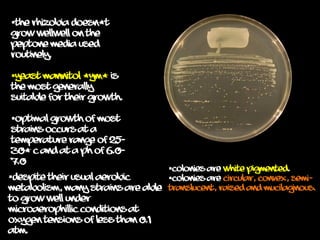
The rhizobia doesn’t
grow wellwell on the
peptone media used
routinely.
Yeast mannitol (YM) is
the most generally
suitable for their growth.
Optimal growth of most
strains occurs at a
temperature range of 25-
30° C and at a pH of 6.0-
7.0
Colonies are white pigmented.
Colonies are circular, convex, semi-
translucent, raised and mucilaginous.
Despite their usual aerobic
metabolism, many strains are able
to grow well under
microaerophillic conditions at
oxygen tensions of less than 0.1
atm.

Rhizobium are symbiotic, nitrogen-fixing bacteria that associate with legumes to enhance their growth by fixing atmospheric nitrogen. The nodulation process involves chemical recognition, root hair curling, and formation of infection threads, leading to the development of root nodules where nitrogen fixation occurs. Their growth is optimized in specific media and conditions, and they utilize various protective mechanisms to thrive in oxygen-rich environments.